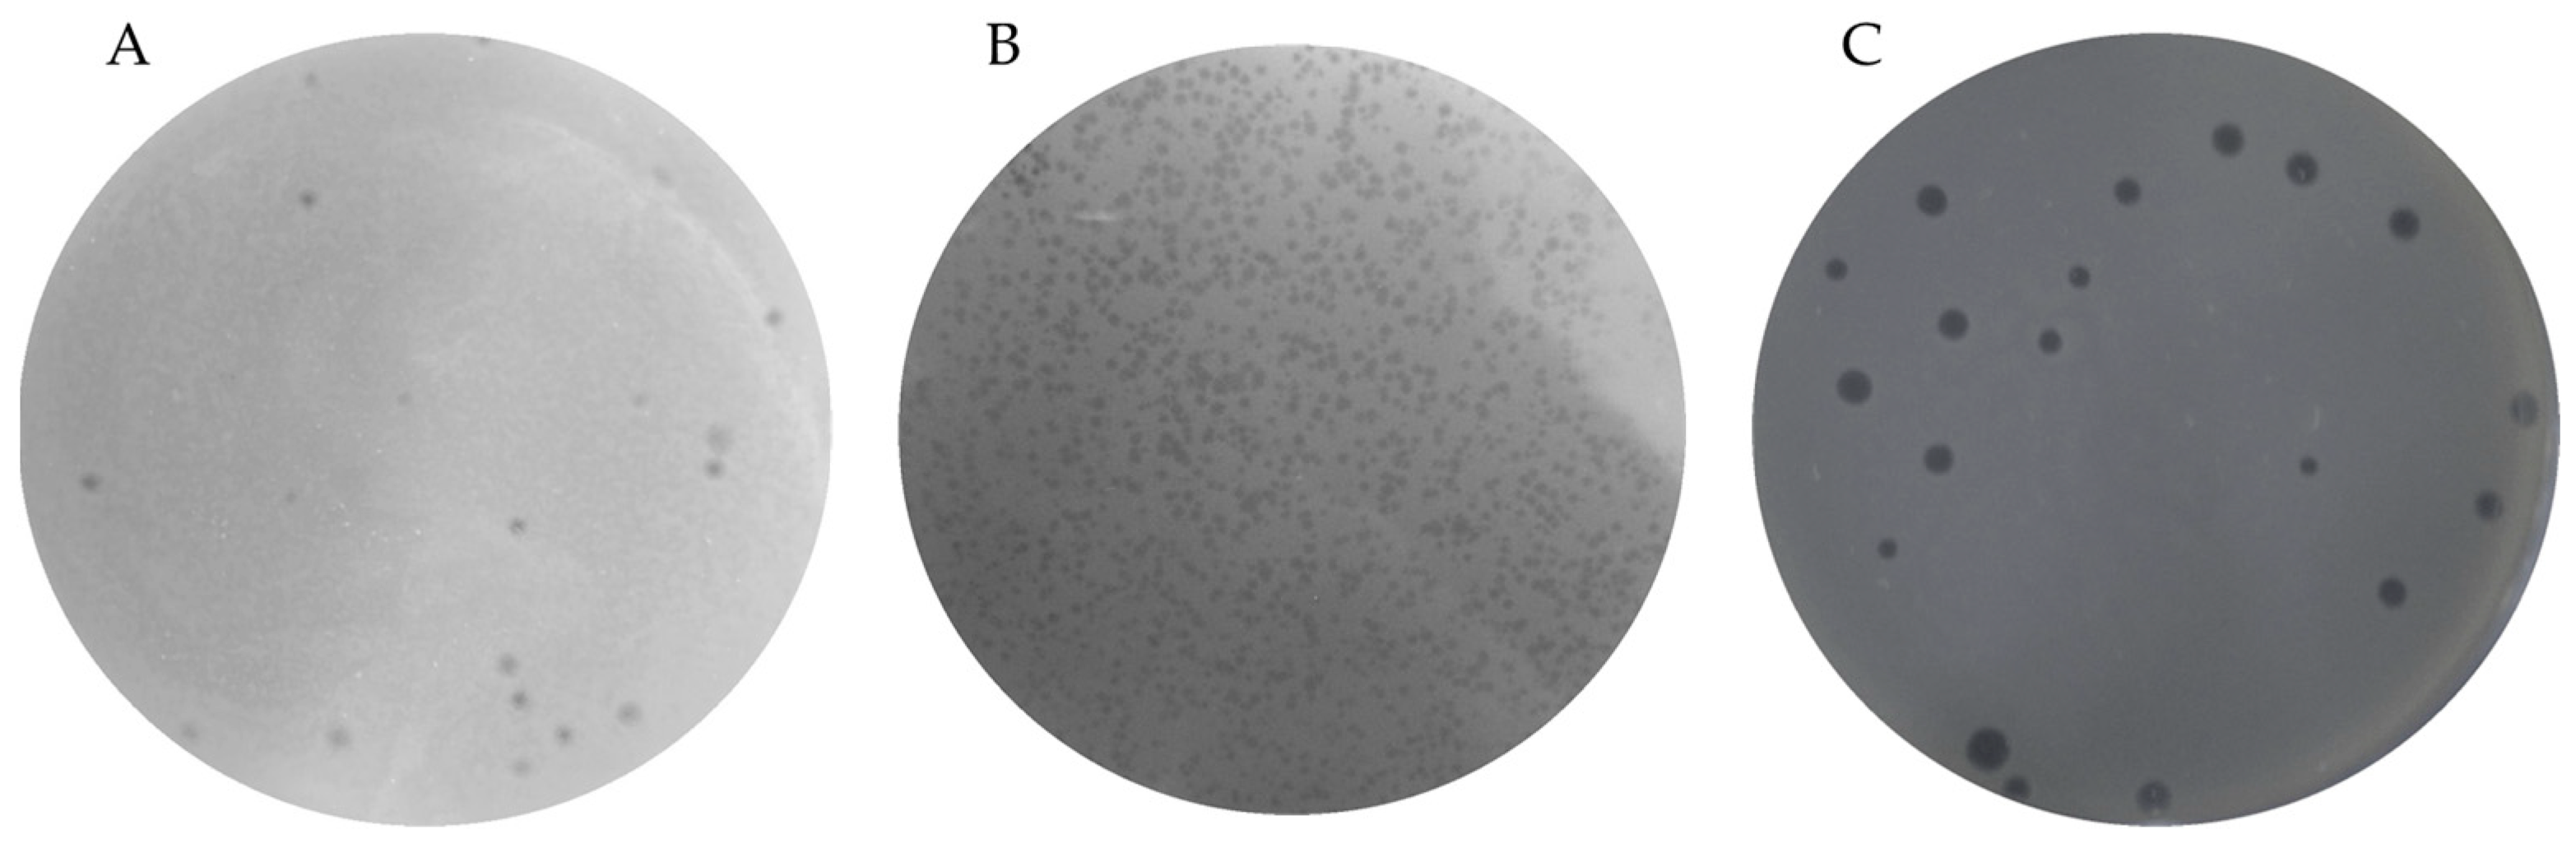
Microorganisms 12 00895 g001

Partial Characterization of Three Bacteriophages Isolated from Aquaculture Hatchery Water and Their Potential in the Biocontrol of Vibrio spp.
Abstract
1. Introduction
2. Materials and Methods
2.1. Isolation and Identification of Vibrio spp.
2.2. Isolation of Vibrio Infecting Phages
2.3. Determination of Phage–Host Specificity
2.4. One-Step Growth Curve
2.5. Effects of Temperature and pH on Phage Stability
2.6. Analysis of Scanning Electron Micrographs of Phage Infection
2.7. Optimal Multiplicity of Infection (MOI) Determination
2.8. Anti-Biofilm Activity of Phages against Vibrio spp.
2.9. Antibacterial Effects of Phages against Planktonic Vibrio spp.
2.10. Statistical Analysis
3. Results
3.1. Rapid Detection of Vibrio spp.
3.2. Isolation and Partial Characterization of Vibrio-Infecting Phages
3.3. In Vitro Phage Treatment Assays
4. Discussion
5. Conclusions
Supplementary Materials
Author Contributions
Funding
Data Availability Statement
Acknowledgments
Conflicts of Interest
References
- Boyd, C.E.; McNevin, A.A.; Davis, R.P. The contribution of fisheries and aquaculture to the global protein supply. Food Secur. 2022, 14, 805–827. [Google Scholar] [CrossRef]
- Ramasamy, H.; Chellam, B.; Heo, M. Molecular studies, disease status and prophylactic measures in grouper aquaculture: Economic importance, diseases, and immunology. Aquaculture 2010, 309, 1–14. [Google Scholar] [CrossRef]
- Mugimba, K.K.; Byarugaba, D.K.; Mutoloki, S.; Evensen, Ø.; Munang’andu, H.M. Challenges and solutions to viral diseases of finfish in marine aquaculture. Pathogens 2021, 10, 673. [Google Scholar] [CrossRef]
- Baker-Austin, C.; Oliver, J.D.; Alam, M.; Ali, A.; Waldor, M.K.; Qadri, F.; Martinez-Urtaza, J. Vibrio spp. infections. Nat. Rev. Dis. Primers 2018, 4, 119. [Google Scholar] [CrossRef] [PubMed]
- Yaashikaa, P.R.; Saravanan, A.; Kumar, P.S. Isolation and identification of Vibrio cholerae and Vibrio parahaemolyticus from prawn (Penaeus monodon) seafood: Preservation strategies. Microb. Pathog. 2016, 99, 5–13. [Google Scholar] [CrossRef] [PubMed]
- Kim, J.Y.; Lee, J.L. Correlation of total bacterial and Vibrio spp. populations between fish and water in the aquaculture system. Front. Mar. Sci. 2017, 4, 147. [Google Scholar] [CrossRef]
- Froelich, B.A.; Daines, D.A. In hot water: Effects of climate change on Vibrio–human interactions. Environ. Microbiol. 2020, 22, 4101–4111. [Google Scholar] [CrossRef]
- Loo, K.Y.; Law, J.W.F.; Tan, L.T.H.; Pusparajah, P.; Wong, S.H.; Chan, K.G.; Lee, L.H.; Letchumanan, V. The burden of Vibrio sp. infections—A scoping review. Prog. Microbes Mol. Biol. 2023, 6, 1–25. [Google Scholar] [CrossRef]
- Loo, K.Y.; Letchumanan, V.; Law, J.W.F.; Pusparajah, P.; Goh, B.H.; Ab Mutalib, N.S.; He, Y.W.; Lee, L.H. Incidence of antibiotic resistance in Vibrio spp. Rev. Aquac. 2020, 12, 2590–2608. [Google Scholar] [CrossRef]
- Elmahdi, S.; DaSilva, L.V.; Parveen, S. Antibiotic resistance of Vibrio parahaemolyticus and Vibrio vulnificus in various countries: A review. Food Microbiol. 2016, 57, 128–134. [Google Scholar] [CrossRef]
- Gxalo, O.; Digban, T.O.; Igere, B.E.; Olapade, O.A.; Okoh, A.I.; Nwodo, U.U. Virulence and antibiotic resistance characteristics of Vibrio isolates from rustic environmental freshwaters. Front. Cell Infect. Microbiol. 2021, 11, 732001. [Google Scholar] [CrossRef] [PubMed]
- Haifa-Haryani, W.O.; Amatul-Samahah, M.A.; Azzam-Sayuti, M.; Chin, Y.K.; Zamri-Saad, M.; Natrah, I.; Amal, M.N.A.; Satyantini, W.H.; Ina-Salwany, M.Y. Prevalence, antibiotics resistance and plasmid profiling of Vibrio spp. isolated from cultured shrimp in Peninsular Malaysia. Microorganisms 2022, 10, 1851. [Google Scholar] [CrossRef] [PubMed]
- Ashrafudoulla, M.; Mizan, M.F.R.; Park, S.H.; Ha, S.D. Current and future perspectives for controlling Vibrio biofilms in the seafood industry: A comprehensive review. Crit. Rev. Food Sci. Nutr. 2021, 61, 1827–1851. [Google Scholar] [CrossRef] [PubMed]
- Abe, K.; Nomura, N.; Suzuki, S. Biofilms: Hot spots of horizontal gene transfer (HGT) in aquatic environments, with a focus on a new HGT mechanism. FEMS Microbiol. Ecol. 2020, 96, fiaa031. [Google Scholar] [CrossRef] [PubMed]
- Higuera, G.; Bastías, R.; Tsertsvadze, G.; Romero, J.; Espejo, R.T. Recently discovered Vibrio anguillarum phages can protect against experimentally induced vibriosis in Atlantic salmon, Salmo salar. Aquaculture 2013, 392, 128–133. [Google Scholar] [CrossRef]
- Doss, J.; Culbertson, K.; Hahn, D.; Camacho, J.; Barekzi, N. A review of phage therapy against bacterial pathogens of aquatic and terrestrial organisms. Viruses 2017, 9, 50. [Google Scholar] [CrossRef] [PubMed]
- Ssekatawa, K.; Byarugaba, D.K.; Kato, C.D.; Wampande, E.M.; Ejobi, F.; Tweyongyere, R.; Nakavuma, J.L. A review of phage mediated antibacterial applications. Alex. J. Med. 2021, 57, 1–20. [Google Scholar] [CrossRef]
- Katharios, P.; Kalatzis, P.G.; Kokkari, C.; Sarropoulou, E.; Middelboe, M. Isolation and characterization of a N4-like lytic bacteriophage infecting Vibrio splendidus, a pathogen of fish and bivalves. PLoS ONE 2017, 12, e0190083. [Google Scholar] [CrossRef] [PubMed]
- Echeverría-Vega, A.; Morales-Vicencio, P.; Saez-Saavedra, C.; Alvarez, M.A.; Gordillo, F.; Del-Valle, R.; Solís, M.E.; Araya, R. Characterization of the Bacteriophage vB_VorS-PVo5 Infection on Vibrio ordalii: A Model for Phage-Bacteria Adsorption in Aquatic Environments. Front. Microbiol. 2020, 11, 550979. [Google Scholar] [CrossRef]
- Jacquemot, L.; Bettarel, Y.; Monjol, J.; Corre, E.; Halary, S.; Desnues, C.; Bouvier, T.; Ferrier-Pagès, C.; Baudoux, A.C. Therapeutic potential of a new jumbo phage that infects Vibrio coralliilyticus, a widespread coral pathogen. Front. Microbiol. 2018, 9, 415995. [Google Scholar] [CrossRef]
- Chen, L.; Fan, J.; Liu, Q.; Yuan, S.; Zhang, H.; Huang, S.; Ma, Y. Isolation and characterization of specific phages to prepare a cocktail preventing Vibrio sp. Va-F3 infections in shrimp (Litopenaeus vannamei). Front. Microbiol. 2019, 10, 482159. [Google Scholar] [CrossRef] [PubMed]
- Veyrand-Quirós, B.; Gómez-Gil, B.; Lomeli-Ortega, C.O.; Escobedo-Fregoso, C.; Millard, A.D.; Tovar-Ramírez, D.; Balcázar, J.L.; Quiroz-Guzmán, E. Use of bacteriophage vB_Pd_PDCC-1 as biological control agent of Photobacterium damselae subsp. damselae during hatching of longfin yellowtail (Seriola rivoliana) eggs. J. Appl. Microbiol. 2020, 129, 1497–1510. [Google Scholar] [CrossRef] [PubMed]
- Cui, H.; Xu, Y.; Cong, C.; Li, C.; Li, X.; Li, S.; Li, J.; Wang, L. Evaluation of the preventive effect of phage cocktails on turbot ascites and its influence on main physiological indicators. Aquaculture 2022, 547, 737539. [Google Scholar] [CrossRef]
- Gomez-Gil, B.; Roque, A. Isolation, enumeration, and preservation of the Vibrionaceae. Biol. Vibrios 2006, 13–26. [Google Scholar] [CrossRef]
- Thompson, J.R.; Randa, M.A.; Marcelino, L.A.; Tomita-Mitchell, A.; Lim, E.; Polz, M.F. Diversity and dynamics of a north atlantic coastal Vibrio community. Appl. Environ. Microbiol. 2004, 70, 4103–4110. [Google Scholar] [CrossRef] [PubMed]
- Frank, J.A.; Reich, C.I.; Sharma, S.; Weisbaum, J.S.; Wilson, B.A.; Olsen, G.J. Critical evaluation of two primers commonly used for amplification of bacterial 16S rRNA genes. Appl. Environ. Microbiol. 2008, 74, 2461–2470. [Google Scholar] [CrossRef] [PubMed]
- Karaynir, A.; Salih, H.; Bozdoğan, B.; Güçlü, Ö.; Keskin, D. Isolation and characterization of Brochothrix phage ADU4. Virus Res. 2022, 321, 198902. [Google Scholar] [CrossRef]
- Montso, P.K.; Mlambo, V.; Ateba, C.N. Characterization of lytic bacteriophages infecting multidrug-resistant shiga toxigenic atypical Escherichia coli O177 strains isolated from cattle feces. Front. Public Health 2019, 7, 484104. [Google Scholar] [CrossRef] [PubMed]
- Mateus, L.; Costa, L.; Silva, Y.J.; Pereira, C.; Cunha, A.; Almeida, A. Efficiency of phage cocktails in the inactivation of Vibrio in aquaculture. Aquaculture 2014, 424, 167–173. [Google Scholar] [CrossRef]
- Kropinski, A.M. Practical Advice on the One-Step Growth Curve. Methods Mol. Biol. 2018, 1681, 41–47. [Google Scholar] [CrossRef]
- Yamaki, S.; Kawai, Y.; Yamazaki, K. Characterization of a novel bacteriophage, Phda1, infecting the histamine-producing Photobacterium damselae subsp. damselae. J. Appl. Microbiol. 2015, 118, 1541–1550. [Google Scholar] [CrossRef] [PubMed]
- Shatila, F.; Yaşa, İ.; Yalçın, H.T. Biofilm Formation by Salmonella enterica Strains. Curr. Microbiol. 2021, 78, 1150–1158. [Google Scholar] [CrossRef] [PubMed]
- Zhang, Y.; Ding, Y.; Li, W.; Zhu, W.; Wang, J.; Wang, X. Application of a novel lytic podoviridae phage Pu20 for biological control of drug-resistant Salmonella in liquid eggs. Pathogens 2021, 10, 34. [Google Scholar] [CrossRef] [PubMed]
- O’Toole, G.A. Microtiter dish biofilm formation assay. J. Vis. Exp. 2011, 47, 2437. [Google Scholar] [CrossRef] [PubMed]
- Ture, M.; Altinok, I.; Cebeci, A.; Caliskan, N. Characterization of novel bacteriophage HP-T19 that targets Hafnia alvei. Aquac. Res. 2022, 53, 694–699. [Google Scholar] [CrossRef]
- Santos, L.; Ramos, F. Antimicrobial resistance in aquaculture: Current knowledge and alternatives to tackle the problem. Int. J. Antimicrob. Agents 2018, 52, 135–143. [Google Scholar] [CrossRef] [PubMed]
- Watts, J.E.M.; Schreier, H.J.; Lanska, L.; Hale, M.S. The rising tide of antimicrobial resistance in aquaculture: Sources, sinks and solutions. Mar. Drugs 2017, 15, 158. [Google Scholar] [CrossRef]
- Reverter, M.; Sarter, S.; Caruso, D.; Avarre, J.C.; Combe, M.; Pepey, E.; Pouyaud, L.; Vega-Heredía, S.; de Verdal, H.; Gozlan, R.E. Aquaculture at the crossroads of global warming and antimicrobial resistance. Nat. Commun. 2020, 11, 1870. [Google Scholar] [CrossRef] [PubMed]
- Schar, D.; Zhao, C.; Wang, Y.; Larsson, D.G.J.; Gilbert, M.; van Boeckel, T.P. Twenty-year trends in antimicrobial resistance from aquaculture and fisheries in Asia. Nat. Commun. 2021, 12, 5384. [Google Scholar] [CrossRef] [PubMed]
- Chuah, L.O.; Effarizah, M.E.; Goni, A.M.; Rusul, G. Antibiotic Application and Emergence of Multiple Antibiotic Resistance (MAR) in Global Catfish Aquaculture. Curr. Environ. Health Rep. 2016, 3, 118–127. [Google Scholar] [CrossRef]
- Pereira, C.; Moreirinha, C.; Lewicka, M.; Almeida, P.; Clemente, C.; Cunha, Â.; Delgadillo, I.; Romalde, J.L.; Nunes, M.L.; Almeida, A. Bacteriophages with potential to inactivate Salmonella Typhimurium: Use of single phage suspensions and phage cocktails. Virus Res. 2016, 220, 179–192. [Google Scholar] [CrossRef] [PubMed]
- Culot, A.; Grosset, N.; Gautier, M. Overcoming the challenges of phage therapy for industrial aquaculture. Aquaculture 2019, 513, 734423. [Google Scholar] [CrossRef]
- Kowalska, J.D.; Kazimierczak, J.; Sowińska, P.M.; Wójcik, E.A.; Siwicki, A.K.; Dastych, J. Growing trend of fighting infections in aquaculture environment—Opportunities and challenges of phage therapy. Antibiotics 2020, 9, 301. [Google Scholar] [CrossRef] [PubMed]
- Glonti, T.; Pirnay, J.-P. In Vitro Techniques and Measurements of Phage Characteristics That Are Important for Phage Therapy Success. Viruses 2022, 14, 1490. [Google Scholar] [CrossRef] [PubMed]
- Ramos-Vivas, J.; Superio, J.; Galindo-Villegas, J.; Acosta, F. Phage therapy as a focused management strategy in aquaculture. Int. J. Mol. Sci. 2021, 22, 436. [Google Scholar] [CrossRef] [PubMed]
- Wang, Q.; Wang, X.; Zhang, J.; Song, G. LNA real-time PCR probe quantification of hepatitis B virus DNA. Exp. Ther. Med. 2012, 3, 503–508. [Google Scholar] [CrossRef]
- Chu, S.V.; Vu, S.T.; Nguyen, H.M.; Le, N.T.; Truong, P.T.; Vu, V.T.; Phung, T.T.; Nguyen, A.T. Fast and Sensitive Real-Time PCR Detection of Major Antiviral-Drug Resistance Mutations in Chronic Hepatitis B Patients by Use of a Predesigned Panel of Locked-Nucleic-Acid TaqMan Probes. J. Clin. Microbiol. 2021, 59, 10–1128. [Google Scholar] [CrossRef]
- Zhang, R.; Ou, X.; Sun, X.; Shen, X.; Zhao, Y.; Ma, X. Multiplex LNA probe-based RAP assay for rapid and highly sensitive detection of rifampicin-resistant Mycobacterium tuberculosis. Front. Microbiol. 2023, 14, 1141424. [Google Scholar] [CrossRef]
- Liu, X.; You, C.; Zeng, Y. Isolation and Identification of Pathogenic Vibrio Species in Black Rockfish Sebastes schlegeli. Fishes 2023, 8, 235. [Google Scholar] [CrossRef]
- Xu, Y.; Yu, Y.; Wang, Y.; Wang, C.; Li, Y.; Liu, D.; Qin, L.; Zhang, Z. Establishment of Multiple Microfluidic Fluorescence Quantitative PCR Detection Technology for Five Main Mariculture Bacterial Pathogens. Prog. Fish. Sci. 2023, 44, 222–234. [Google Scholar] [CrossRef]
- Zhang, X.H.; He, X.; Austin, B. Vibrio harveyi: A serious pathogen of fish and invertebrates in mariculture. Mar. Life Sci. Technol. 2020, 2, 231–245. [Google Scholar] [CrossRef] [PubMed]
- Kapetanović, D.; Vardić Smrzlić, I.; Gavrilović, A.; Jug-Dujaković, J.; Perić, L.; Kazazić, S.; Mišić Radić, T.; Kolda, A.; Čanković, M.; Žunić, J.; et al. Characterization of Vibrio Populations from Cultured European Seabass and the Surrounding Marine Environment with Emphasis on V. anguillarum. Microorganisms 2022, 10, 2159. [Google Scholar] [CrossRef] [PubMed]
- Hansen, M.J.; Kudirkiene, E.; Dalsgaard, I. Analysis of 44 Vibrio anguillarum genomes reveals high genetic diversity. PeerJ 2020, 8, e10451. [Google Scholar] [CrossRef] [PubMed]
- Qiao, G.; Lee, D.C.; Woo, S.H.; Li, H.; Xu, D.H.; Park, S.I. Microbiological characteristics of Vibrio scophthalmi isolates from diseased olive flounder Paralichthys olivaceus. Fish. Sci. 2012, 78, 853–863. [Google Scholar] [CrossRef]
- Zhang, Z.; Yu, Y.X.; Wang, Y.G.; Liu, X.; Wang, L.F.; Zhang, H.; Liao, M.J.; Li, B. Complete genome analysis of a virulent Vibrio scophthalmi strain VSc190401 isolated from diseased marine fish half-smooth tongue sole, Cynoglossus semilaevis. BMC Microbiol. 2020, 20, 341. [Google Scholar] [CrossRef] [PubMed]
- Novianty, R.I.; Budiarti, S. Lytic bacteriophage for Photobacterium damselae isolated from water environment. Int. J. Innov. Res. Sci. Eng. 2014, 2, 549–553. [Google Scholar]
- Gallet, R.; Kannoly, S.; Wang, I.N. Effects of bacteriophage traits on plaque formation. BMC Microbiol. 2011, 11, 181. [Google Scholar] [CrossRef] [PubMed]
- Stone, E.; Campbell, K.; Grant, I.; Mcauliffe, O. Understanding and Exploiting Phage-Host Interactions. Viruses 2019, 11, 567. [Google Scholar] [CrossRef] [PubMed]
- Albrycht, K.; Rynkiewicz, A.A.; Harasymczuk, M.; Barylski, J.; Zielezinski, A. Daily Reports on Phage-Host Interactions. Front. Microbiol. 2022, 13, 946070. [Google Scholar] [CrossRef]
- Harper, D.R. Criteria for Selecting Suitable Infectious Diseases for Phage Therapy. Viruses 2018, 10, 177. [Google Scholar] [CrossRef]
- Ferriol-González, C.; Domingo-Calap, P. Phages for biofilm removal. Antibiotics 2020, 9, 268. [Google Scholar] [CrossRef] [PubMed]
- Manoharadas, S.; Ahmad, N.; Altaf, M.; Alrefaei, A.F.; Al-Rayes, B.F. An Enzybiotic cocktail effectively disrupts preformed dual biofilm of Staphylococcus aureus and Enterococcus faecalis. Pharmaceuticals 2023, 16, 564. [Google Scholar] [CrossRef] [PubMed]
- Yang, M.; Chen, H.; Huang, Q.; Xie, Z.; Liu, Z.; Zhang, J.; Ding, Y.; Chen, M.; Xue, L.; Wu, Q.; et al. Characterization of the novel phage vB_VpaP_FE11 and its potential role in controlling Vibrio parahaemolyticus biofilms. Viruses 2022, 14, 264. [Google Scholar] [CrossRef] [PubMed]
- Silva, Y.J.; Costa, L.; Pereira, C.; Mateus, C.; Ngela Cunha, A.; Calado, R.; Gomes, N.C.M.; Pardo, M.A.; Hernandez, I.; Almeida, A. Phage Therapy as an Approach to Prevent Vibrio anguillarum Infections in Fish Larvae Production. PLoS ONE 2014, 9, e114197. [Google Scholar] [CrossRef] [PubMed]
- Suh, G.A.; Lodise, T.P.; Tamma, P.D.; Knisely, J.M.; Alexander, J.; Aslam, S.; Barton, K.D.; Bizzell, E.; Totten, K.M.C.; Campbell, J.L.; et al. Considerations for the Use of Phage Therapy in Clinical Practice. Antimicrob. Agents Chemother. 2022, 66, e02071-21. [Google Scholar] [CrossRef]
- McCallin, S.; Sacher, J.C.; Zheng, J.; Chan, B.K. Current State of Compassionate Phage Therapy. Viruses 2019, 11, 343. [Google Scholar] [CrossRef]

| Code | Sequence 5′-3′ | Tm (°C) | Target | Reference |
|---|---|---|---|---|
| 567 F | GGC GTA AAG CGC ATG CAG GT | 61.4 | 16S rDNA | [25] |
| 680 R | GAA ATT CTA CCC CCC TCT ACA G | 54.3 | 16S rDNA | |
| Vsp P | TTA AGT CAG ATG TGA AAG CCC GGG | 59.4 | 16S rDNA | This study |
| Host Range | Vibrio Phages | ||
|---|---|---|---|
| IKEM_vK | IKEM_v14 | IKEM_v5 | |
| V. harveyi | |||
| Gdp1 (PP270122) | + | ||
| Gdp6 (PP270125) | + | ||
| Gdp14 (PP270130) | + | ||
| Gdp17 (PP270133) | + | ||
| Gdp22 (PP270137) | + | ||
| Gdp25 (PP270139) | + | ||
| Gdp28 (PP270140) | + | ||
| Gdp29 (PP270141) | + | ||
| V. anguillarum | |||
| Gdp19 (PP270135) | + | ||
| Gdp20 (PP270136) | + | ||
| Gdp30 (PP270142) | + | ||
| Gdp34 (PP270146) | + | ||
| V. scophtalmi | |||
| Gdp33 (PP270145) | + | ||
| Gdp35 (PP270147) | + | ||
| Gdp38 (PP270150) | + | ||
| Gdp39 (PP270151) | + | ||
| V. alginolyticus | |||
| Gdp18 (PP270134) | + | ||
| Gdp24 (PP270138) | + | ||
| V. azureus | |||
| Gdp32 (PP270144) | + | ||
| V. ordalii | |||
| Gdp41 (PP270152) | + | + | |
| V. neonatanus | |||
| Gdp42 (PP270153) | |||
Disclaimer/Publisher’s Note: The statements, opinions and data contained in all publications are solely those of the individual author(s) and contributor(s) and not of MDPI and/or the editor(s). MDPI and/or the editor(s) disclaim responsibility for any injury to people or property resulting from any ideas, methods, instructions or products referred to in the content. |
© 2024 by the authors. Licensee MDPI, Basel, Switzerland. This article is an open access article distributed under the terms and conditions of the Creative Commons Attribution (CC BY) license (https://creativecommons.org/licenses/by/4.0/).
Share and Cite
Yaşa, İ.; Evran, S.; Eren Eroğlu, A.E.; Önder, C.; Allahyari, M.; Menderes, G.; Kullay, M. Partial Characterization of Three Bacteriophages Isolated from Aquaculture Hatchery Water and Their Potential in the Biocontrol of Vibrio spp. Microorganisms 2024, 12, 895. https://doi.org/10.3390/microorganisms12050895
Yaşa İ, Evran S, Eren Eroğlu AE, Önder C, Allahyari M, Menderes G, Kullay M. Partial Characterization of Three Bacteriophages Isolated from Aquaculture Hatchery Water and Their Potential in the Biocontrol of Vibrio spp. Microorganisms. 2024; 12(5):895. https://doi.org/10.3390/microorganisms12050895
Chicago/Turabian StyleYaşa, İhsan, Serap Evran, Asiye Esra Eren Eroğlu, Cengiz Önder, Maryam Allahyari, Gülçin Menderes, and Müberra Kullay. 2024. "Partial Characterization of Three Bacteriophages Isolated from Aquaculture Hatchery Water and Their Potential in the Biocontrol of Vibrio spp." Microorganisms 12, no. 5: 895. https://doi.org/10.3390/microorganisms12050895
APA StyleYaşa, İ., Evran, S., Eren Eroğlu, A. E., Önder, C., Allahyari, M., Menderes, G., & Kullay, M. (2024). Partial Characterization of Three Bacteriophages Isolated from Aquaculture Hatchery Water and Their Potential in the Biocontrol of Vibrio spp. Microorganisms, 12(5), 895. https://doi.org/10.3390/microorganisms12050895

